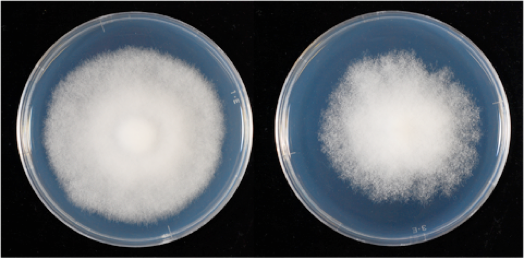

2.ジャガイモ疫病菌の種類

日本のジャガイモ疫病菌にはどのような種類があるのか?
日本では各地のジャガイモ畑で疫病の発生が見られますが、その原因となる菌は同じものなのでしょうか。
これまでも、日本のジャガイモ疫病菌には2つの種類があることがわかっていました。1990 年代になると、さらに新しい種類が増えていることが明らかになってきました。私たちの研究室では日本の疫病菌集団の構造を明らかにするために次のような遺伝マーカーを使って、日本の畑から分離された菌を類別することを試みました。


ジャガイモ疫病菌はこれらの遺伝子型ごとに特徴的な性質を持っていることがわかってきています(現在発表準備中)。
遺伝子型の決定方法も年々進歩しており、現在ではマイクロサテライト解析で判別が可能です。
これらの遺伝子型の分布などについては次のページで示します。
